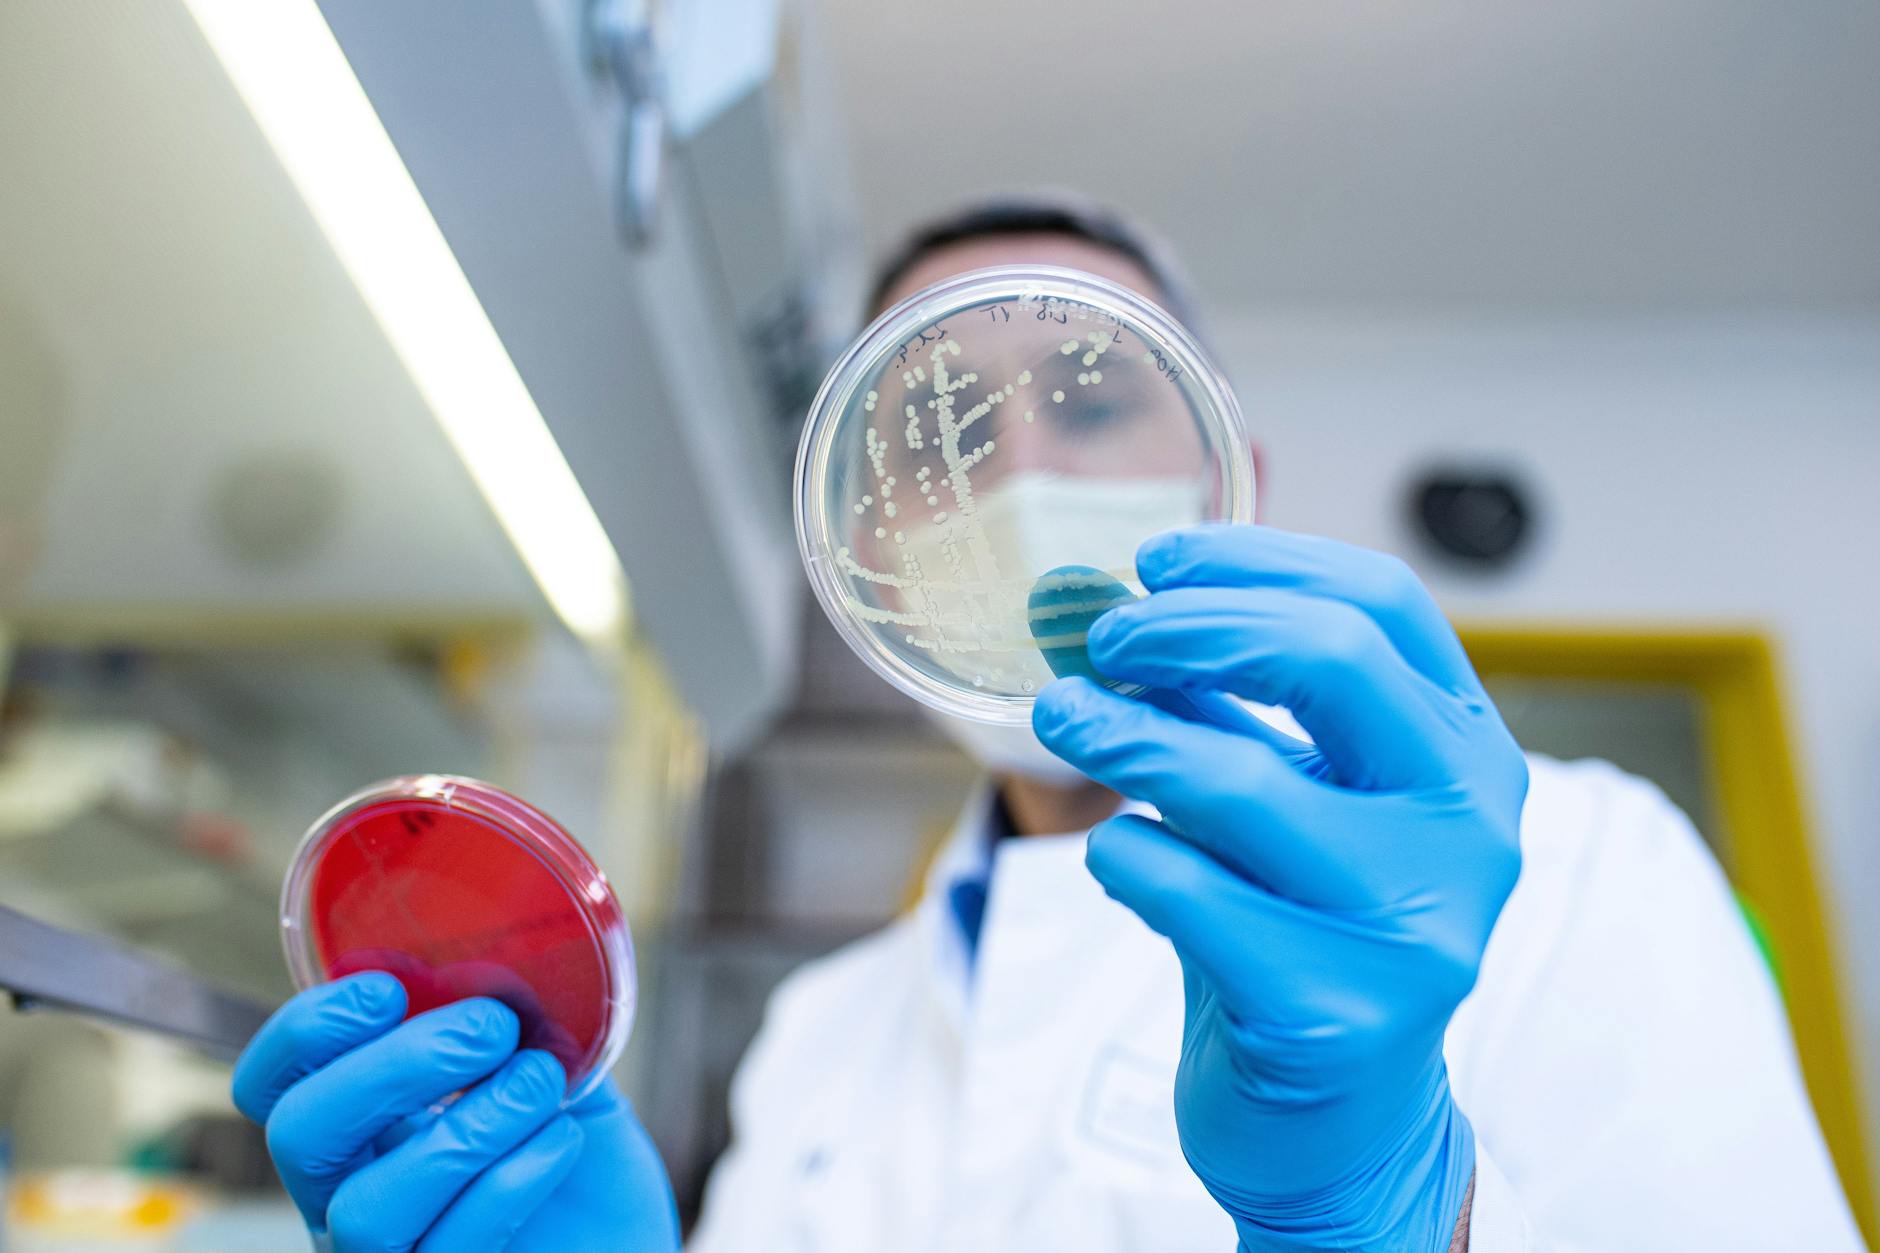
Die Suche nach der Quelle der Erreger, die die aktuellen Ehec-Welle auslösten, dauert noch an.

Ehec-Alarm in Deutschland! In den letzten Wochen steigt die Zahl der Infizierten wieder stark an, auch Belgien meldet viele Fälle! Die Ursache ist noch unbekannt. Doch jetzt ruft auch ein Hersteller eine Wurstsorte zurück, die mit dem Erreger der schlimmstenfalls sogar tödlich verlaufenden Darmerkrankungen verseucht war. Wiederholt sich der große Ehec-Ausbruch in Deutschland von 2011?
Thüringer Wurst wurde bundesweit verkauft
Seit Tagen geht in Ostdeutschland wieder die Ehec-Angst um, seitdem 17 Fälle in Mecklenburg-Vorpommern gemeldet wurden. Doch nun wird der Erreger auch aus Thüringen gemeldet. Dort hat die Schleizer Fleisch- und Wurstwaren GmbH ihre Zwiebelmettwurst in der 500-Gramm-Packung zurück gerufen. In einer Charge mit dem Mindesthaltbarkeitsdatum 27.8.2025 wurden Ehec-Bakterien nachgewiesen, teilte das Unternehmen mit.
Vom Verzehr der Wurst wird dringend abgeraten. Verkauft wurde die Wurst auch in Brandenburg, nach Berlin wurde sie den Angaben des Unternehmens nach jedoch nicht ausgeliefert. Kunden können die Zwiebelmettwurst laut Mitteilung im Handel abgeben und bekommen ihr Geld zurück.

Ehec: Wer ist besonders gefährdet?
Ehec steht bestimmte Escherichia-coli-Bakterien, die starke Zellgifte produzieren. Die Gifte können im Darm schwere Entzündungen und schwere Durchfallerkrankungen auslösen. Im schlimmsten Fall führen sie zu Nierenversagen und sogar zum Tod. Vom Verzehr verseuchter Lebensmittel bis zum Ausbruch der Erkrankung dauert es im Durchschnitt drei bis vier Tage. Kinder sind besonders gefährdet, weil ihr Immunsystem und ihre Organe noch nicht ausgereift sind. Auch bei Vorerkrankten und älteren Menschen sind schwerere Verläufe häufig.
In Deutschland und in Belgien ist die Zahl der Erkrankungen zuletzt stark angestiegen. Fast 40 Fälle wurden vor allem in Mecklenburg-Vorpommern und in Belgien bekannt. In belgischen Seniorenheimen erkrankten etwa 20 Menschen an den Bakterien, mindestens fünf Menschen starben. In Mecklenburg-Vorpommern sind vor allem Kinder betroffen, manchen ringen in Kliniken auf der Intensivstation um ihr Leben.
Droht neuer großer Ehec-Ausbruch?
Wie und ob die Ausbrüche in Deutschland und Belgien zusammenhängen, könne man zum jetzigen Zeitpunkt noch nicht sagen, sagt der Vorsitzende der Deutschen Gesellschaft für Pädiatrische Infektiologie, Tobias Tenenbaum. Allgemein seien Kitas und Seniorenheime besonders sensible Bereiche für Durchfallerkrankungen. „Es braucht noch eine gewisse Zeit, um herauszufinden, was die Ursache ist“, so der Kinderarzt.